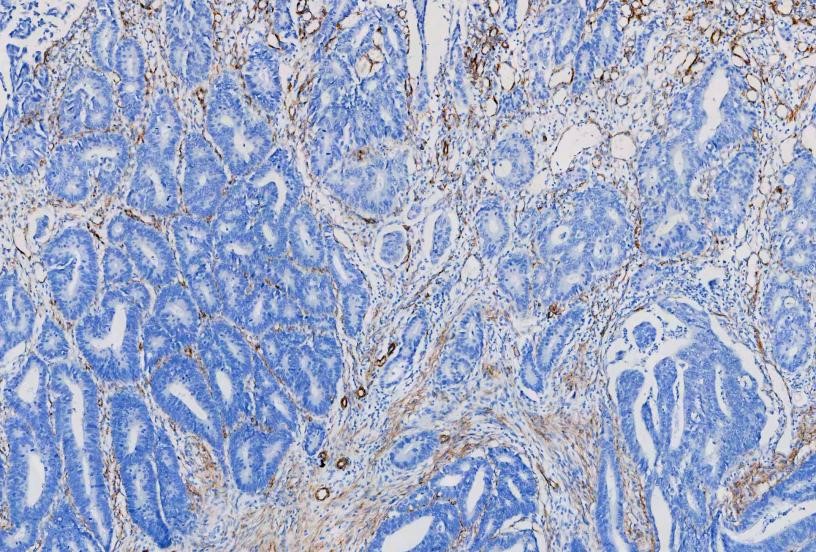

This website uses cookies to ensure you get the best experience on our website.
- Table of Contents
IHC Protocol Deep-dive:
Antigen retrieval is a vital technique in immunohistochemistry (IHC) that enhances the visibility of antigens in formalin-fixed, paraffin-embedded (FFPE) tissue samples. During fixation, formaldehyde creates cross-links that mask epitopes—the specific regions of antigens recognized by antibodies. This masking impairs antibody access to these critical sites, limiting effective binding and impacting staining results. In professional IHC services, optimized antigen retrieval conditions are applied as part of a standardized workflow to ensure consistent, interpretable staining across FFPE tissue samples.
To address this, antigen retrieval methods are
employed to reverse the cross-linking and restore antigenicity. These
techniques allow antibodies to bind more effectively to their target antigens,
improving sensitivity and accuracy in detection. While fixation is essential
for preserving tissue morphology, it can negatively affect protein
biochemistry, altering the conformation or electrostatic charge of epitopes and
further hindering antibody interaction. Thus, antigen retrieval is necessary to
ensure reliable diagnostic and research outcomes by overcoming the challenges
posed by the fixation process.
Antigen retrieval breaks protein cross-links, unmasking epitopes and improving antibody access. This enhances staining intensity, restores antigen detectability, and ensures reliable IHC results. It is particularly essential for FFPE samples where fixation alters protein structure and electrostatic properties.
HIER is the most widely used technique for antigen retrieval. This method utilizes heat to reverse the cross-linking that occurs during tissue fixation. Typically, tissue samples are immersed in a buffer solution, such as sodium citrate or EDTA, and subjected to heating using a microwave, pressure cooker, or water bath. The heat denatures proteins and breaks the cross-links, effectively unmasking the epitopes and allowing antibodies to bind more efficiently.
Microwave heat retrieval is highly effective for most antigens. It works in two ways: microwave radiation induces polar movement in molecules, aiding in the breakdown of aldehyde bonds. The rapid heat generated by this molecular motion, upon reaching a sufficient temperature, can denature proteins fixed with formaldehyde. This technique is known for its quick heat generation, simplicity of use, and the possibility of causing the antigen retrieval solution to boil.
Critical factors in HIER include the temperature, pH, and incubation time, all of which must be carefully optimized to ensure proper antigen unmasking without causing morphological damage. Common buffers used in HIER include sodium citrate (10 mM, pH 6), EDTA (1 mM, pH 8), and Tris/EDTA (pH 9), with temperatures typically reaching 95-100 °C.
In contrast to HIER, PIER employs proteolytic enzymes, such as bromelain, aspronase, pepsin, ficin, trypsin, proteinase K, or other proteases, to digest the proteins surrounding the epitopes. This enzymatic treatment selectively breaks down specific protein structures, thereby exposing the masked epitopes. PIER is often considered a gentler approach compared to HIER, making it suitable for fragile tissues. However, careful optimization of enzyme concentration, incubation temperature, and incubation time is required to achieve optimal results.
Choosing the appropriate proteolytic enzymes depends on the specific antigen components being targeted. Typically, pepsin and bromelain are used to detect interstitial antigens like fibronectin, laminin (LN), and various types of collagen. Other proteolytic enzymes can be used to identify intracellular antigens. It's crucial to consider the optimal pH for each enzyme to ensure effective digestion.
There are two common methods of epitope retrieval: heat-induced epitope retrieval (HIER), and proteolytic-induced epitope retrieval (PIER). Selecting the right method is critical to get the best results for your application
| heat-induced epitope retrieval (HIER) | proteolytic-induced epitope retrieval (PIER) | |
| Advantage | A broader range of antigens, especially nuclear and high-molecular-weight proteins less likely to disrupt tissue morphology produce less non-specific staining | Preferred for difficult-to-recover epitopes less damaging to delicate or fragile tissues, suitable for certain types of samples |
| Disadvantage | Overheating can damage tissues or lead to loss of antigenicity, while insufficient heating may result in inadequate retrieval | the low success rate for restoring immunoreactivity potential for destroying both tissue morphology and the antigen of interest |
| Difficulties | Unequal retrieval due to unequal heating | Concentration calibration |
The pH of the retrieval solution used in antigen heat retrieval can significantly impact staining results. The effects of pH on staining can generally be classified into four categories:
1. Stable Type: pH has minimal effect on staining results, as seen with PCNA, AE1, EMA, and CD20.
2. V Type: Both high and low pH values yield good staining results, while pH values around 4-5 result in poorer staining, as observed with ER and Ki-67.
3. Increasing Type: Staining results improve progressively with increasing pH, such as with HMB45.
4. Decreasing Type: Staining results weaken as pH increases; this is rare and seen with antibodies like MOC31.
Currently, the most commonly used retrieval solutions are
citrate buffer and EDTA buffer. Studies indicate that for most antibodies, EDTA
(pH 8.0 or 9.0) is more effective than citrate at pH 6.0, especially for
nuclear-positive antibodies. However, due to traditional practices, most hospitals
and laboratories continue to use citrate buffer at pH 6.0.
Optimal retrieval conditions depend on
the type of tissue, fixation, and antibody, necessitating optimization for each
antigen. To optimize antigen retrieval, preliminary studies should be conducted
using a matrix of various combinations of time, temperature, and pH.
Here is an example of a matrix.
| Time | Antigen Retrieval Solution pH | Antigen Retrieval Solution pH | Antigen Retrieval Solution pH |
|---|---|---|---|
| pH6.0 | pH8.0 | pH9.0 | |
| 4 minutes | Slide #1 | Slide #2 | Slide #3 |
| 8 minutes | Slide #4 | Slide #5 | Slide #6 |
| 12 minutes | Slide #7 | Slide #8 | Slide #9 |
Microwave heat retrieval is a commonly used Heat-Induced Epitope Retrieval (HIER) method. The following protocol uses it as an example. Optimal conditions always have to be determined by each laboratory and in accordance with the specific product information.
Materials:
Steps:
1.Immerse the slides in staining dish containing antigen retrieval buffer.
2.Microwave the staining dish at 95°C for 8 minutes.
3.Cool the slides for 5 minutes.
4.Microwave the staining dish at 95°C for 4 minutes.
5.Cool the slides to room temperature before proceeding with staining.
Note: Steamer, water bath or
pressure cooker can be used as alternative heating source to replace microwave.
Proteolysis-Induced Epitope Retrieval (PIER)
PIER requires careful optimization of
enzyme concentration, incubation temperature, and incubation time to achieve
optimal results. Trypsin is a commonly used enzymatic antigen retrieval
solution. The following protocol uses 0.1% trypsin as an example. Optimal
conditions always have to be determined by each laboratory and in accordance
with the specific product information.
Materials and reagents
37°C incubator
Humidified chamber
Enzymatic antigen retrieval solution
1.Prepare the 0.1% trypsin solution and preheat it to 37°C.
2. Pipette the enzyme solution onto the tissue section.
3. Place the slides in a humidified container and then into a 37°C incubator.
4. After 10-30 minutes, remove the slides and transfer them to a rack in a container of
tap water.
5. Rinse under running water for 3 minutes.
6. Proceed with the immunohistochemical staining.



Example Applications:
IHC analysis of PCNA using anti-PCNA antibody (MA1083). PCNA was detected in a paraffin-embedded section of human rectal cancer tissue. The tissue section was blocked with 5% BSA. The tissue section was then incubated with 1μg/ml mouse anti-PCNA Antibody (MA1083) overnight at 4°C. Peroxidase Conjugated Goat Anti-Mouse IgG was used as a secondary antibody and incubated for 30 minutes at 37°C. The tissue section was developed using the HRP Conjugated Mouse IgG Super Vision Assay Kit (Catalog # SV0001) with DAB as the chromogen.

IHC analysis of
Alpha-Smooth Muscle Actin using anti-Alpha-Smooth Muscle Actin antibody
(MA1106). Alpha-Smooth Muscle Actin was detected in a paraffin-embedded section
of human rectal cancer tissues. The tissue section was blocked with 5% BSA. The
tissue section was then incubated with 1μg/ml mouse anti-Alpha-Smooth Muscle
Actin Antibody (MA1106) overnight at 4°C. Peroxidase Conjugated Goat Anti-Mouse
IgG was used as secondary antibody and incubated for 30 minutes at 37°C. The
tissue section was developed using HRP Conjugated Mouse IgG Super Vision Assay
Kit (Catalog # SV0001) with DAB as the chromogen.
IHC optimization is a critical step in any test. This guide gives you insight on antigen retrieval, fixation and embedding. Learn how to optimize your immunohistochemistry test to get valuable results.
See MoreThe principle behind Immunohistochemistry (IHC) entails detection of antigen or happens in cells of a tissue section by exploiting the principle of antibodies binding specifically to antigens in biological tissues. Learn more about this in this guide.
See MoreThis guide provides a thorough list of Immunohistochemistry troubleshooting tips, including weak staining, high background, nonspecific staining among others. Learn how to take control of your IHC process.
See MoreBosterBio has a detailed stepwise IHC protocol with a clearly illustrated IHC workflow with recommended reagents. Learn how to effectively implement a successful immunostaining for tissue sections and cell climbing slices.
See MoreIHC images show the detection of CD3E in paraffin-embedded human tonsil sections following incubation of tissue for 5 and 15 minutes at 95°C in the specified antigen retrieval solution. If you need an acidic antigen retrieval buffer, check out Boste...
See MoreTroubleshooting guides Optimizing your Antigen Retrieval Method Greetings Earthling, Here are some technical tips for optimizing your antigen retrieval method! To find the optimal antigen recovery method, we suggest that you test both HIER and PIER m...
See MoreIHC Enzyme Antigen Retrieval Reagent is an IHC enzymatic antigen unmasking reagent composed of multiple proteinases used for enzymatic digestion of tissue and proteins in proteolytic induced epitope retrieval (PIER). AR0022
See MoreAfter saturation, the inactivated antibody replaces the primary antibody in the IHC protocol for the control. The samples are incubated with only the antibody diluent without adding the primary antibody. No Primary Controls No primary controls (aka s...
See More